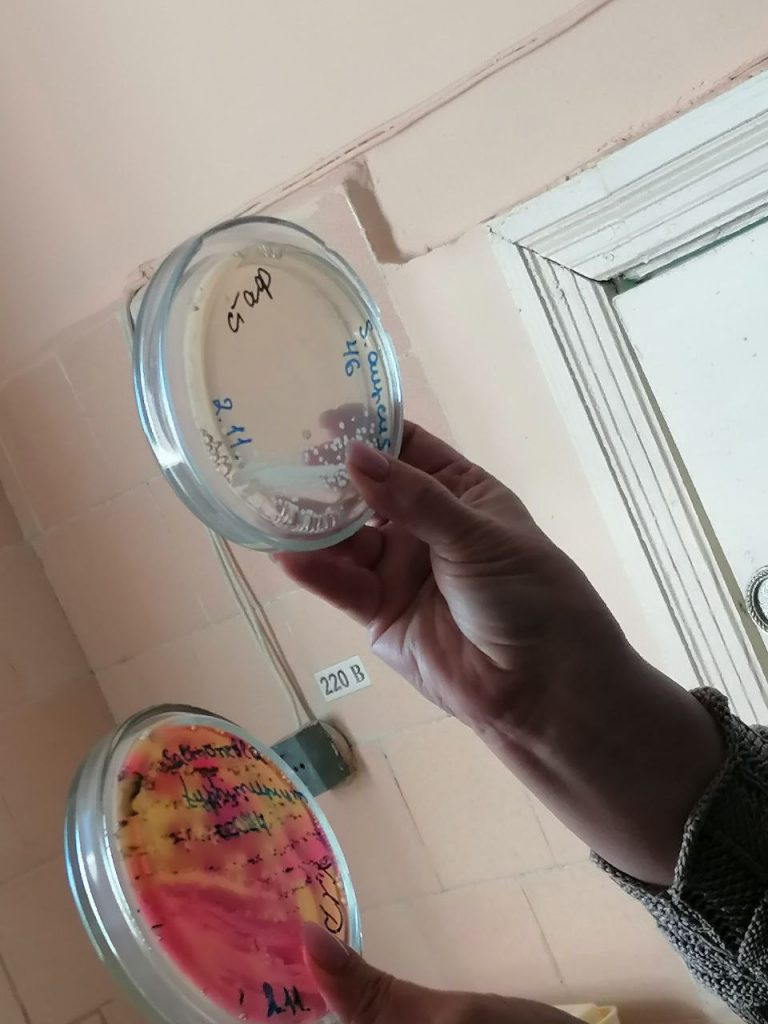

Ребят встретила Ланина Лариса Борисовна, главный врач Филиал ФБУЗ «Центр гигиены и эпидемиологии в Тамбовской области» в городе Рассказово, городе Кирсанове, Рассказовском, Кирсановском, Гавриловском, Уметском и Бондарском районах. Беседа была очень содержательной.
Ребята узнали о медицинской микробиологии, которой занимаются специалисты Центра гигиены и эпидемиологии. Они изучают состояние почвы, воды, воздуха, а также обследуют людей. Остановились на особенностях восприимчивости человеческого организма к микробам, сделав акцент на правильном, здоровом образе жизни.
Ребята посетили помещения учреждения, увидели специальное оборудование для стерилизации и исследования микроорганизмов. Юным биологам рассказали о том, что микромир изучается микроскопами различной мощности. Микробов сначала выращивают, а потом изучают. Посмотрели ребята, какие бывают микробы и как они растут в разной питательной среде.
В завершении встречи Лариса Борисовна выразила надежду на, что ребята выберут в будущем профессию, связанную с медициной или системой роспотребнадзора, поэтому им обязательно нужно знать микробиологию.